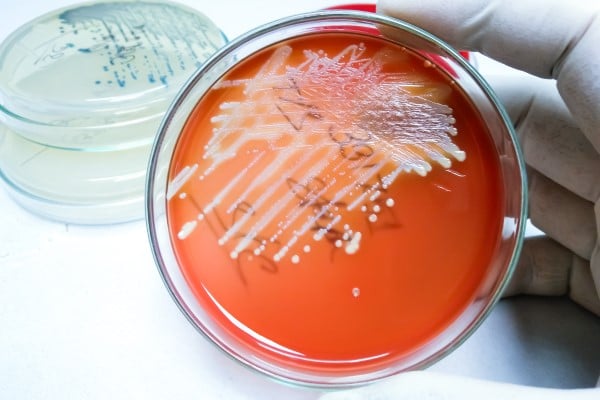
A petri dish with a bacteria sample

We know your heart.
Heart surgery is something no one should have to face alone. And at MetroHealth, you don’t have to.
What sets our cardiothoracic surgery program apart from others is the way we work as a team—including the patient—to review your situation and determine the best route for treatment. At MetroHealth, you’re not bounced around from specialist to specialist. Instead, your primary care provider, cardiologist, and surgeon will see you as an individual who needs personalized care.
Even though surgery can be an overwhelming time, rest easy knowing that at MetroHealth, we stand out for our incredible outcomes, short hospital stays, and quality post-operative care. Our robust and detailed system for patient evaluation and care before, during, and after surgery shows that we don’t just see you as someone with heart disease—we see you as someone with a healthy life to look forward to. And, our social workers are excellent at assisting patients in finding rehabilitation and home healthcare options as they recover from surgery.
What To Know About Cardiothoracic Surgery
Many types of heart disease can be treated via cardiothoracic surgery, sometimes called open heart surgery. Often, your cardiologist will work to find minimally-invasive or non-invasive treatments for the symptoms you’re experiencing. However, the severity of your heart disease may require surgery to give you the best chance at a healthy outcome.
At MetroHealth, we provide surgical solutions for the following diagnoses:

Coronary Artery Disease
The most common type of heart disease treated with cardiothoracic surgery, coronary artery disease means the arteries that supply blood to your heart have narrowed or are blocked.

Valvular Heart Disease
A broad term to describe problems with the four valves that control bloodflow in your heart, valves can narrow, leak, or bulge into the heart chamber.

Heart Failure
Heart failure doesn’t mean your heart has stopped working, but it does mean your heart can’t pump enough blood to meet your body’s needs.

Aortic Aneurism
A bulge in the main artery that carries blood from your heart.

Arrythmia
Arrythmia is an abnormal heart rhythm—whether your heart beats too fast, too slow, or in an irregular fashion.

Pericardial Disease
Your heart is surrounded by a fluid-filled sac that protects it. Pericardial disease happens when that sac becomes inflamed.
Endocarditis
Endocarditis occurs when a bacterial or fungal infection causes inflammation on the inner lining of your heart.
Cardiothoracic surgery is an option for patients who have severe heart disease, or aren’t good candidates for medical treatment or devices. At MetroHealth, each patient receives individual counseling from their team—including primary care providers, cardiologists, and cardiothoracic surgeons—to understand treatment options and how your body may respond.
Surgical procedures we perform at MetroHealth include:

Coronary Artery Bypass Grafting
For patients with coronary artery disease, surgeons will take a healthy blood vessel from your leg, arm, or chest and use it to bypass your blocked coronary artery.

Valve Replacement
If your heart valves are leaking, bulging, or narrowing, we can replace the valves with biological or mechanical valves—depending on your personal situation.

TAVR
For aortic stenosis, TAVR—or Transcatheter Aortic Valve Replacement—is a minimally invasive produce durée that replaces your aortic valve with an artificial valve through a small catheter inserted into a small incision.

Maze Procedure
When devices and ablation for A-Fib and other arrythmia isn’t effective, the Maze Procedure uses high-energy waves to create scar tissue on your heart that blocks faulty electrical signals that causes irregular heartbeat.

Vegectomy
For patients who cannot replace valves damaged by endocarditis because they are too sick, vegectomy is a surgery to remove the growths caused by infection.

Pericardiectomy
When the pericardium becomes thickened due to infection, surgeons can remove it through surgery.
Advancing Research
MetroHealth participates in many clinical research studies to understand heart disease and disease management, sharing those results with the international medical community.

A team dedicated to you.
The MetroHealth Heart and Vascular Center is setting a new standard of care in northeast Ohio.
